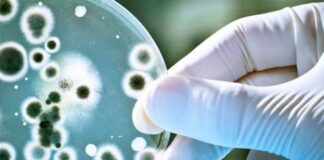
Difteria

El aceite de onagra proviene de la onagra o prímula (Oenothera Biennis). Pertenece a la familia de las onagráceas y es originaria del norte de América. Los primeros en usarlas fueron los indios nativos americanos y no fue hasta el siglo XVII cuando llegó a Europa. Eso sí, con fines ornamentales. Un siglo después, comienza a consumirse por la falta de alimento a raíz de las guerras de aquellos tiempos.
Alto en vitamina E ideal para fortalecer el sistema inmunológico
INDICACIONES
Aunque su eficacia no está cien por cien demostrada, la principal característica que se le atribuye es un poder analgésico. De ahí que lo utilicen muchas mujeres para aliviar los dolores menstruales y para tratar el síndrome premenstrual.
Sin embargo, también se suele utilizar para tratar problemas de la piel, como los eccemas, el acné o la psoriasis y en patologías como la artritis reumatoide o la osteoporosis, para aliviar sus síntomas.
Algunas personas también lo utilizan en el síndrome de fatiga crónica, el asma, el trastorno de déficit de atención e hiperactividad (TDAH) o la obesidad. Durante el embarazo, las mujeres lo utilizan para prevenir la hipertensión, aunque la mayoría sin evidencia científica contrastada.
COMPOSICIÓN
Estas propiedades del aceite de Onagra en la mejora de la comodidad femenina radican en su alto contenido en ácidos grasos esenciales poliinsaturados. Se trata, fundamentalmente, de ácido linoleico (con presencia entre el 65% y el 80%) y gamma linolénico (entre el 8% y el 14%), ambos pertenecientes al grupo de los Omega 6. El ácido linoleico se encuentra también en frutos secos como cacahuetes, almendras, nueces, aguacate, aceites de girasol y de maíz. Por su parte, el ácido gamma linolénico lo podemos encontrar en el aceite de borraja.
Recuerda que los ácidos grasos esenciales (AGE) deben incluirse en nuestra dieta puesto que nuestro organismo no los sintetiza. Pese a ello, además de tener un papel fundamental para el correcto funcionamiento de las células del organismo y del cerebro, protegen nuestro corazón, de modo que son fundamentales.
BENEFICIOS
La principal razón por la cual el aceite de onagra, ha repuntado su popularidad en los últimos años, se debe a las propiedades que se han descubierto, las cuales le conceden la oportunidad al ser humano de lidiar con una diversidad de problemas y malestares, tanto a nivel interno como externo. Entre dichas propiedades que este aceite posee, podemos encontrar:
Vaso Dilatador:
El consumo de este aceite aumenta el tamaño de los vasos sanguíneos que recorren el cuerpo, encargados de trasportar la sangre llevando nutrientes y oxígeno. Esta es la razón por la cual, el aceite reduce las posibilidades de sufrir enfermedades sanguíneas y coronarias como trombos o alta presión arterial.
Regulador:
Debido a la presencia de ácidos grasos esenciales, este aceite le concede al cuerpo y regula en él, elementos necesarios para su buen funcionamiento como el aceite omega 6. Aparte, ayuda a regular los niveles de colesterol malo en la sangre y se considera capaz de equilibrar los niveles hormonales, lo que tiene un efecto positivo en el síndrome premenstrual y en la menopausia.
Antiinflamatorio y Analgésico:
Este aceite ofrece la posibilidad de combatir las inflamaciones en todo el cuerpo, sobre todo, las musculares y las articulares. El efecto del aceite de onagra llega al sistema nervioso, siendo útil para aliviar dolores y molestias que se pueden sufrir, sobre todo, cuando se trata del síndrome premenstrual.
Mejora la salud de la piel y fortalece el cuero cabelludo:
Este aceite es útil para aliviar y luchar contra diversas afecciones cutáneas, ayudando a reducir el acné y desaparecer manchas de la piel. Aparte, ayuda a controlar la producción de grasa y contribuye al rejuvenecimiento. Este efecto es posible, gracias a la presencia de minerales y vitaminas que ayudan a controlar la caída del cabello y que también se presenta como un arma contra la caspa
Fortalece el sistema inmunológico:
Este aceite contribuye a vigorizar y mejorar las defensas naturales del organismo.
USOS
La onagra se usa como planta medicinal desde hace siglos, decíamos, antes como infusión preparada con las hojas y las flores. Se le atribuían efectos sedantes y propiedades astringentes útiles para las molestias gastrointestinales.
Lo más frecuente y extendido, a día de hoy, son las perlas de aceite de onagra. Cada distribuidor recomienda una ingesta preferente, por ejemplo, tomar dos perlas al día durante la mañana, sin especificar que sea antes o después de comer. En otros casos se recomiendan tres cápsulas al día, una después de cada comida. No hay un criterio unificado.
En estudios sobre su efecto en la dermatitis atópica se ha administrado una dosis de entre seis y ocho gramos al día en adultos, y entre dos y cuatro en niños, durante un tiempo superior a tres meses.
Además de la administración por vía oral, estudios clínicos han demostrado su eficacia por la vía tópica. Sobre todo, en afecciones de la piel como el eccema atópico. También se utiliza en productos cosméticos, más aún los que se venden como útiles para combatir el envejecimiento de la piel.
Leer también: